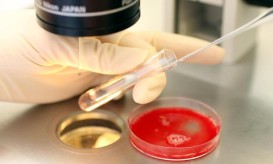

Δείτε ποιες τροφές σας πειράζουν!
Μπορεί για κάποιους ορισμένες τροφές να αποτελούν βάλσαμο και για άλλους να είναι φαρμάκι. Σύμφωνα με επιστημονικά στοιχεία το 40-50%...

Μπορεί για κάποιους ορισμένες τροφές να αποτελούν βάλσαμο και για άλλους να είναι φαρμάκι. Σύμφωνα με επιστημονικά στοιχεία το 40-50%...

Μια ακόμη αρνητική συνέπεια έχει επιφέρει η κρίση στην χώρα μας. Όλο και περισσότερες Ελληνίδες καθυστερούν να γίνουν μητέρες...
Όταν ο πελαργός δεν χτυπά την πόρτα τότε πολλά ζευγάρια που θέλουν να αποκτήσουν παιδί καταφεύγουν στην εξωσωματική γονιμοποίηση. Σύμφωνα...

Μια από τις πιο σοβαρές κληρονομικές παθήσεις είναι η Μεσογειακή αναιμία η οποία μεταδίδεται στο παιδί από γονείς υγιείς,...

Μόλις μάθατε τα ευχάριστα νέα. Σε εννέα μήνες θα κρατάτε στην αγκαλιά σας το μωράκι σας. Τη χαρά σας...

''Ό,τι γράφεται στα γονίδια δεν ξεγράφεται'. Τα γονίδια που κληρονομούμαι από τους γονείς μας ευθύνονται για την προδιάθεσή μας...